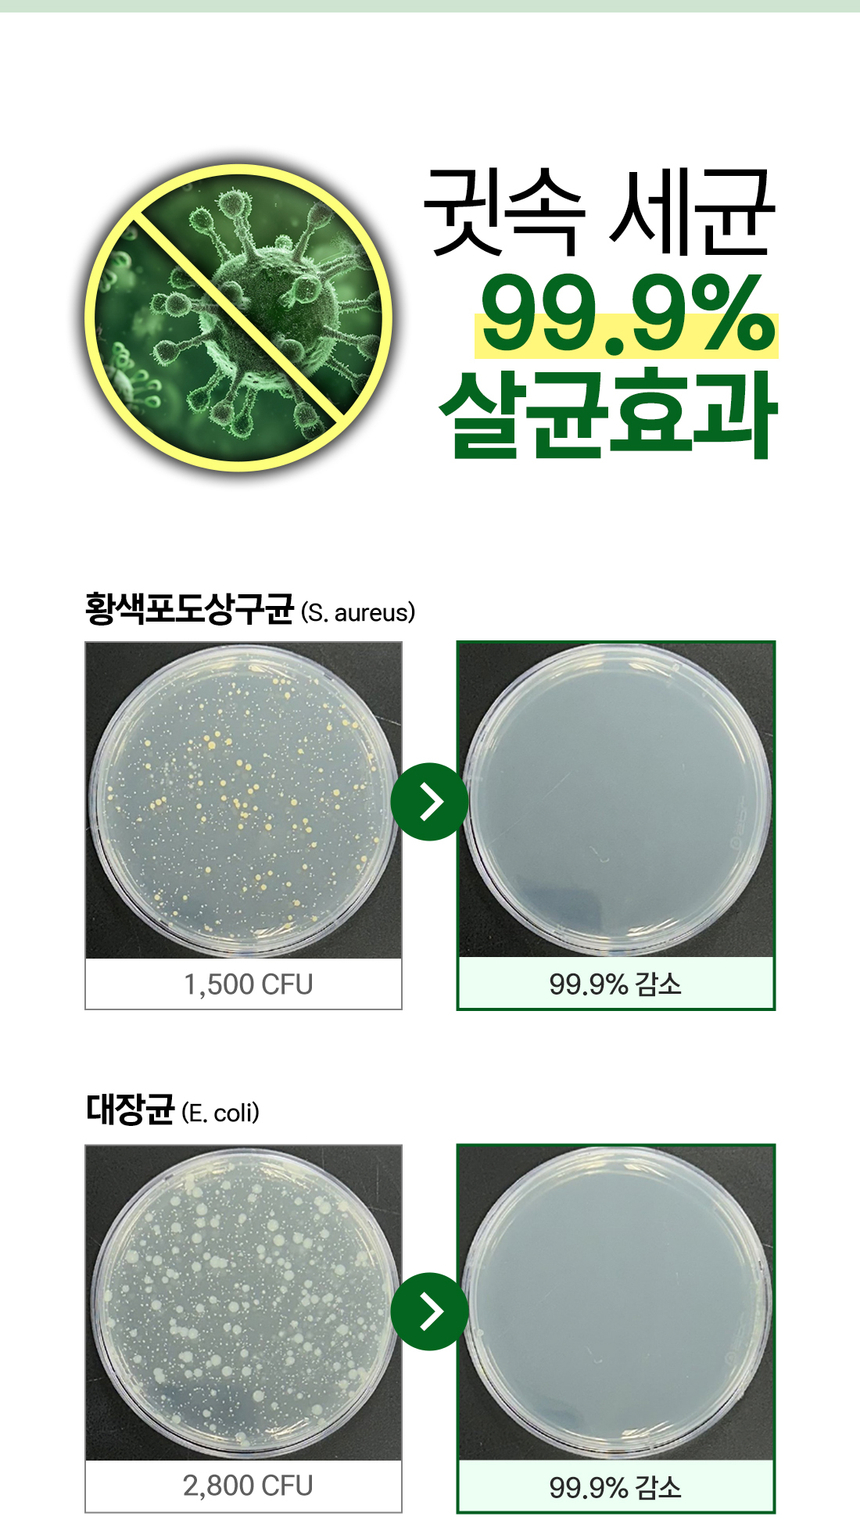

今日の為替レート
お振込銀行
クレジットカード支払い
ログイン | LOGIN
商品カテゴリー
- ブランドファッション
- ファッション/雑貨
- ビューティー
- 食品
- 出産/育児
- 生活雑貨
- パソコン
- レジャー
비코드 데일리 액상면봉 100p 3개 + 비코드 데일리 면봉 300p 1개 덤 / 개별포장 귓속청소 자극없는
|
|||||||||||||||||
| 商品購入についてのご案内 | |||
|
|||
사은품_비코드 데일리 면봉 300p 1개